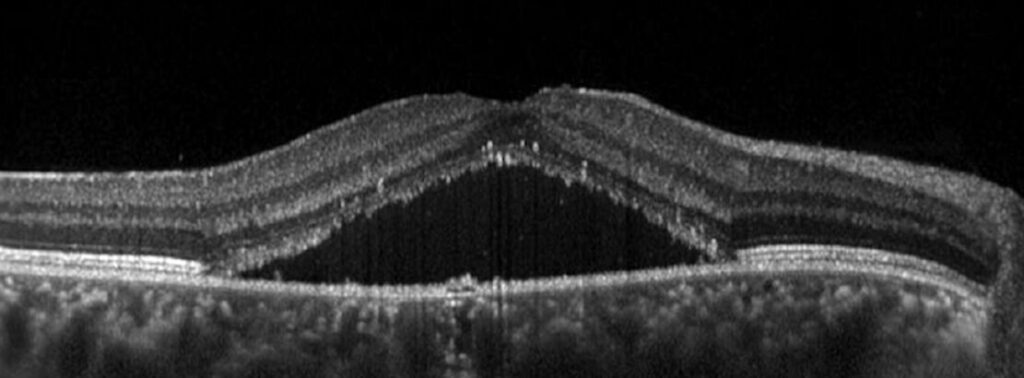
Screenshot 2025-12-08 alle 01.19.56 Corioretinopatia Sierosa Centrale: Sintomi e Trattamenti
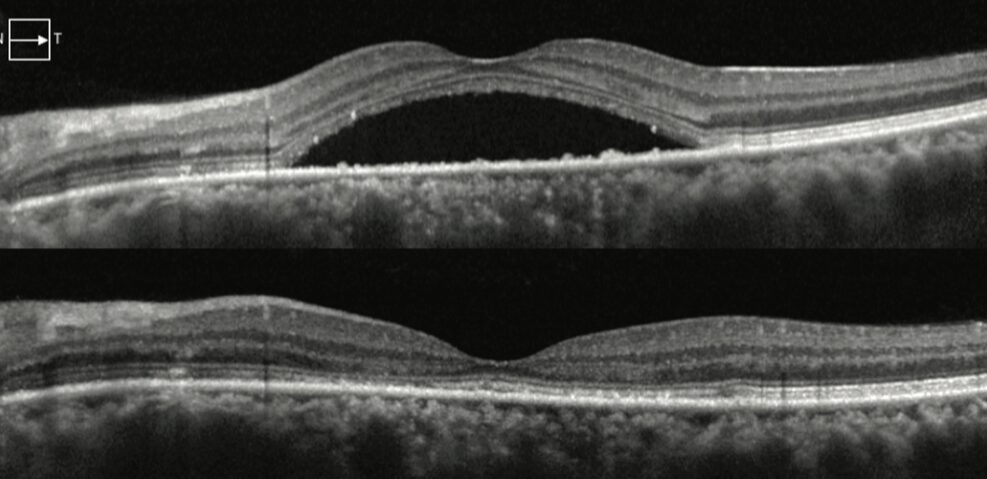
Screenshot 2025-12-08 alle 02.06.23 Corioretinopatia Sierosa Centrale: Sintomi e Trattamenti

- Cosa è la corioretinopatia sierosa centrale?
- Quanto è diffusa e chi colpisce?
- Cause e fattori di rischio
- Perchè si accumula liquido sotto la retina?
- Quali sono i sintomi?
- Come fare diagnosi e quali esami eseguire?
- Come si tratta?
- Quale è la prognosi?
- L'importanza dei controlli periodici
- La corioretinopatia sierosa centrale può avere complicanze?
Ti è mai capitato di vedere macchie scure o una zona sfocata proprio al centro della vista? Potrebbe trattarsi di corioretinopatia sierosa centrale, una condizione oculare che colpisce soprattutto persone giovani ed attive, spesso in momenti di stress. In questo articolo scoprirai cos’è, quali sono i sintomi da non sottovalutare e le cure più efficaci per recuperare la tua visione. Parleremo nel dettaglio di Corioretinopatia Sierosa Centrale.
Cosa è la corioretinopatia sierosa centrale?
La corioretinopatia sierosa centrale (CRSC) è una patologia della retina caratterizzata dall’accumulo di liquido sieroso sotto la regione maculare, cioè la parte centrale responsabile della visione nitida e dei dettagli.
Si tratta di una condizione relativamente frequente che, nella maggior parte dei casi, tende a risolversi spontaneamente nel giro di alcuni mesi. Tuttavia, non è raro che la malattia si ripresenti con recidive o che, in alcuni pazienti, assuma un andamento cronico, con possibili ripercussioni sulla qualità visiva.
Quanto è diffusa e chi colpisce?
La corioretinopatia sierosa centrale (CRSC) è una patologia tipica del giovane adulto, che colpisce più frequentemente tra i 20 ed i 50 anni, con una netta prevalenza nel sesso maschile. Nella maggior parte dei pazienti l’esordio interessa un solo occhio (monolaterale), ma nelle forme croniche non è raro che, con il tempo, venga coinvolto anche l’occhio controlaterale.
Cause e fattori di rischio
Sebbene la corioretinopatia sierosa centrale (CRSC) sia una patologia complessa e multifattoriale, diversi fattori di rischio sono stati identificati:
- Stress: la malattia colpisce spesso persone con personalità di tipo A, competitive ed inclini all’ansia
- Utilizzo di cortisone: indipendentemente dalla modalità di somministrazione (orale, topica, nasale ed oculare), con un rischio proporzionale a dose e durata
- Patologie endocrine: che determinano ipercortisolismo, come la sindrome di Cushing
- Fumo di sigaretta: probabilmente per un effetto vascolare diretto
- Sindrome metabolica: ipertensione arteriosa, obesità ed apnee notturne
- Gravidanza: per modificazioni ormonali
- Infezione da Helicobacter Pilori: alcuni studi sembrano dimostrare una maggiore incidenza di CRSC in pazienti con infezione da parte di questo patogeno
- Ipermetropia: in cui particolari caratteristiche anatomiche dell’occhio possono favorire l’aumento della pressione venosa coroideale.
Perchè si accumula liquido sotto la retina?
La corioretinopatia sierosa centrale (CRSC) è dovuta ad una disfunzione dell’epitelio pigmentato retinico (EPR) ed ad una permeabilità anomala dei capillari coroideali.
L’aumento dei livelli di cortisolo provoca una vasocostrizione che interessa anche la coriocapillare, con incremento della pressione idrostatica e conseguente fuoriuscita di liquidi. Normalmente l’EPR agisce come una pompa fisiologica, eliminando il liquido in eccesso dalla retina centrale verso la coroide. Nella CRSC questo meccanismo risulta compromesso, con accumulo di fluido sottoretinico e distacco sieroso della retina centrale.
Fortunatamente, nella maggior parte dei casi, questa alterazione è temporanea. Dopo alcuni mesi l’EPR recupera la sua funzione, permettendo il riassorbimento spontaneo del liquido.
Quali sono i sintomi?
Come suggerisce il nome, la corioretinopatia sierosa centrale (CRSC) interessa soprattutto la visione centrale, in quanto colpisce la macula. I sintomi riferiti dai pazienti sono tipici e permettono di sospettare rapidamente la diagnosi:
- Offuscamento visivo: il paziente descrive una visione appannata, come se le immagini fossero coperte da una sottile patina
- Riduzione dell’acuità visiva: in genere moderata, ma più grave nei casi cronici
- Metamorfopsie: distorsione delle immagini, linee dritte come stipiti o fughe delle piastrelle appaiono storte o ondulate
- Micropsia: gli oggetti vengono percepiti più piccoli del normale
- Riduzione della sensibilità al contrasto: difficoltà a distinguere chiaramente i dettagli tra chiaro e scuro, anche in buona illuminazione
- Discromatopsia: alterata percezione dei colori, con difficoltà a distinguere le tonalità più sature.


Come fare diagnosi e quali esami eseguire?
La diagnosi di corioretinopatia sierosa centrale (CRSC) inizia sempre con una raccolta accurata dell’anamnesi, volta ad individuare i possibili fattori di rischio, in particolare lo stress o l’utilizzo di corticosteroidi. Successivamente la diagnosi viene confermata attraverso diversi esami:
- Esame del fondo dell’occhio: consente di osservare direttamente la retina e nei casi più evidenti si può notare un tipico distacco sieroso a livello maculare
- OCT: rappresenta il gold standard diagnostico. È un esame rapido, non invasivo ed indolore che ricostruisce in 3D la retina centrale, mostrando con precisione la quantità e l’estensione del liquido sottoretinico
- Angiografia con verde di indocianina (ICGA): prevede l’iniezione di un colorante per analizzare la circolazione retinica e coroideale. Non è più l’esame principale, ma resta utile nei casi dubbi o quando si sospettano complicanze. Presenta aspetti tipici definiti “a macchia d’inchiostro” o “a ciminiera”, legati alla fuoriuscita del colorante dai vasi alterati.

Come si tratta?
Il trattamento della corioretinopatia sierosa centrale (CRSC) all’esordio è nella maggior parte dei casi di tipo conservativo, basato sull’osservazione clinica. Circa il 95% dei pazienti va incontro ad una risoluzione spontanea della malattia nell’arco di pochi mesi. Durante questa fase è fondamentale controllare i fattori predisponenti, in particolare:
- Gestione dello stress: ridurre il carico emotivo e psicologico
- Riduzione o sospensione dei corticosteroidi: quando possibile, in accordo con lo specialista di riferimento.
Se la malattia non si risolve spontaneamente o nei casi più gravi, possono essere presi in considerazione diversi trattamenti specifici:
- Laser micropulsato giallo (MPG): stimola la funzione dell’epitelio pigmentato retinico senza danneggiare i tessuti circostanti, favorendo il riassorbimento del liquido
- Terapia fotodinamica (PDT): utilizzata nei casi cronici o recidivanti. Prevede l’iniezione di verteporfina e l’attivazione con laser, con effetto di “chiusura” delle perdite vascolari.
In alcuni casi possono essere indicati anche:
- Eplerenone: antagonista dei mineralcorticoidi che riduce l’effetto del cortisolo sull’epitelio pigmentato
- Integratori: sostanze antiossidanti come curcumina e zafferano, che possiedono proprietà antinfiammatorie e neuroprotettive, possono essere utilizzati come supporto
- Iniezioni intravitreali di anti-VEGF: indicate nei casi complicati in cui si sviluppi una neovascolarizzazione coroideale, simile a quella osservata nella maculopatia essudativa.

Quale è la prognosi?
Nella maggior parte dei casi la prognosi della corioretinopatia sierosa centrale (CRSC) è favorevole. Oltre il 90% dei pazienti va incontro ad una risoluzione spontanea del primo episodio entro 3-6 mesi. In genere il recupero visivo è buono, spesso completo, anche se in alcuni casi possono persistere lievi disturbi come una ridotta sensibilità al contrasto.
La forma cronica invece ha una prognosi meno positiva, la presenza prolungata di liquido sottoretinico provoca nel tempo una sofferenza delle cellule visive, con rischio di evoluzione verso atrofia retinica e riduzione permanente della qualità visiva.
L’importanza dei controlli periodici
Dopo la diagnosi di corioretinopatia sierosa centrale, il paziente deve essere seguito con OCT periodici, ogni 3 mesi nelle fasi iniziali ed ogni 6-12 mesi quando la situazione si è stabilizzata. Questi controlli permettono di monitorare il riassorbimento del liquido e di individuare subito eventuali recidive o complicanze.
La corioretinopatia sierosa centrale può avere complicanze?
Le complicanze della corioretinopatia sierosa centrale (CRSC) sono rare, ma risultano più frequenti nelle forme croniche o ricorrenti. In questi casi, il prolungato accumulo di liquido sottoretinico ostacola gli scambi di ossigeno e metaboliti tra retina e cellule visive, causando una sofferenza cronica ed un danno progressivo all’epitelio pigmentato retinico (EPR).
Le principali complicanze sono:
- Atrofia retinica: la più comune. È dovuta alla perdita progressiva della funzione dell’EPR ed alla degenerazione delle cellule visive, con riduzione irreversibile dell’acuità visiva
- Neovascolarizzazione coroideale (CNV): rara ma grave. Si sviluppa per la produzione di fattori di crescita (VEGF) che stimolano la formazione di nuovi vasi anomali dalla coroide verso la retina centrale, alterandone la struttura in modo permanente, in modo simile alla maculopatia essudativa.

